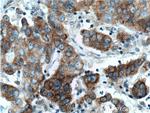
TNK1 Antibody in Immunohistochemistry (Paraffin) (IHC (P))

Search
Proteintech
TNK1 Polyclonal Antibody
{{$productOrderCtrl.translations['antibody.pdp.commerceCard.promotion.promotions']}}
{{$productOrderCtrl.translations['antibody.pdp.commerceCard.promotion.viewpromo']}}
{{$productOrderCtrl.translations['antibody.pdp.commerceCard.promotion.promocode']}}: {{promo.promoCode}} {{promo.promoTitle}} {{promo.promoDescription}}. {{$productOrderCtrl.translations['antibody.pdp.commerceCard.promotion.learnmore']}}
产品信息
14199-1-AP
种属反应
已发表种属
宿主/亚型
分类
类型
抗原
偶联物
形式
浓度
规格
纯化类型
保存液
内含物
保存条件
运输条件
产品详细信息
Immunogen sequence: MLPEAGSLW LLKLLRDIQL AQFYWPILEE LNVTRPEHFD FVKPEDLDGI GMGRPAQRRL SEALKRLRSG PKSKNWVYKI LGGFAPEHKE PTLPSDSPRH LPEPEGGLKC LIPEGAVCRG ELLGSGCFGV VHRGLWTLPS GKSVPVAVKS LRVGPEGPMG TELGDFLREV SVMMNLEHPH VLRLHGLVLG QPLQMVMELA PLGSLHARLT APAPTPPLLV ALLCLFLRQL AGAMAYLGAR GLVHRDLATR NLLLASPRTI KVADFGLVRP LGGARGRYVM GGPRPIPYAW CAPESLRHGA FSSASDVWMF GVTLWEMFSG GEEPWAGVPP YLILQRLEDR ARLPRPPLCS RALYSLALRC WAPHPADRPS FSHLEGLL (1-377 aa encoded by BC035782)
靶标信息
TNK1 tyrosine kinase, non-receptor 1 belongs to the tyrosine protein kinase family and as such is an important regulator of intracellular signal transduction pathways mediating cellular proliferation, survival, and development. TNK1 is highly expressed in fetal tissues and at lower levels in a few adult tissues. TNK1 may function in signaling pathways utilized broadly during fetal development, and more selectively in adult tissues. TNK1 plays a negative regulatory role in the Ras-Raf1-MAPK pathway, and knockout mice have been shown to develop spontaneous tumors, suggesting a role as a tumor suppressor gene.
仅用于科研。不用于诊断过程。未经明确授权不得转售。
生物信息学
蛋白别名: CD38 negative kinase 1; Kinase of embryonic stem cells; MGC46193; non-receptor tyrosine kinase; Non-receptor tyrosine-protein kinase TNK1; tnk1
基因别名: KOS1; TNK1; Tnk1a; Tnk1b
UniProt ID: (Human) Q13470, (Mouse) Q99ML2
Entrez Gene ID: (Human) 8711, (Rat) 303247, (Mouse) 83813